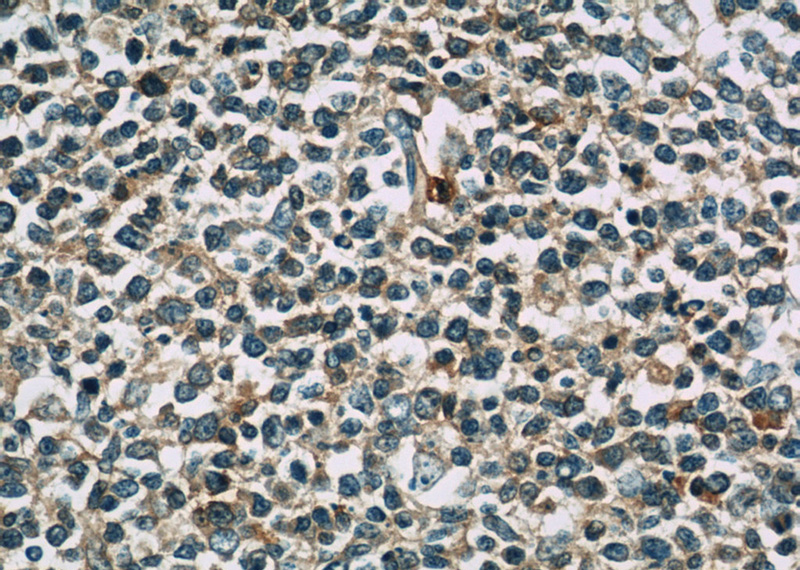
Immunohistochemistry of paraffin-embedded human tonsillitis slide using Catalog No:116287(TNFAIP8 Antibody) at dilution of 1:50

-
Product Name
TNFAIP8 antibody
- Documents
-
Description
TNFAIP8 Rabbit Polyclonal antibody. Positive IHC detected in human lung cancer tissue, human tonsillitis tissue. Positive WB detected in A549 cells, K-562 cells, PC-13 cells. Observed molecular weight by Western-blot: 21-23kd
-
Tested applications
ELISA, WB, IHC
-
Species reactivity
Human,Mouse,Rat; other species not tested.
-
Alternative names
GG2 1 antibody; MDC 3.13 antibody; NDED antibody; SCC S2 antibody; SCCS2 antibody; TNF alpha induced protein 8 antibody; TNF induced protein GG2 1 antibody; TNFAIP8 antibody
-
Isotype
Rabbit IgG
-
Preparation
This antibody was obtained by immunization of TNFAIP8 recombinant protein (Accession Number: NM_001286813). Purification method: Antigen affinity purified.
-
Clonality
Polyclonal
-
Formulation
PBS with 0.1% sodium azide and 50% glycerol pH 7.3.
-
Storage instructions
Store at -20℃. DO NOT ALIQUOT
-
Applications
Recommended Dilution:
WB: 1:200-1:1000
IHC: 1:20-1:200
-
Validations

A549 cells were subjected to SDS PAGE followed by western blot with Catalog No:116287(TNFAIP8 antibody) at dilution of 1:300
Immunohistochemistry of paraffin-embedded human tonsillitis slide using Catalog No:116287(TNFAIP8 Antibody) at dilution of 1:50

Immunohistochemistry of paraffin-embedded human lung cancer slide using Catalog No:116287(TNFAIP8 Antibody) at dilution of 1:50
-
Background
TNFAIP8(tumor necrosis factor, alpha-induced protein 8), also called SCC-S2/GG2-1/NDED, is associated with enhanced cell survival and inhibition of apoptosis. The induction of TNFAIP8 by TNF depends on the activation of NFκB. TNFAIP8 suppresses the TNF-mediated apoptosis by inhibiting caspase-8 activity but not the processing of procaspase-8, subsequently resulting in inhibition of BID cleavage and caspase-3 activation. TNFAIP8 is expressed in adult spleen, lymph node, thymus, thyroid, bone marrow, and placenta, and in fetal liver, lung, and kidney at high levels, also expressed in various tumor tissues and all cancer cell lines tested.
-
References
- Zhang S, Zhang Y, Wei X. Expression and regulation of a novel identified TNFAIP8 family is associated with diabetic nephropathy. Biochimica et biophysica acta. 1802(11):1078-86. 2010.
- Porturas TP, Sun H, Buchlis G. Crucial roles of TNFAIP8 protein in regulating apoptosis and Listeria infection. Journal of immunology (Baltimore, Md. : 1950). 194(12):5743-50. 2015.
Related Products / Services
Please note: All products are "FOR RESEARCH USE ONLY AND ARE NOT INTENDED FOR DIAGNOSTIC OR THERAPEUTIC USE"
